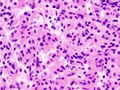
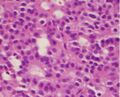

ورم الغدة النخامية
| Pituitary adenoma | |
|---|---|
 | |
| Visual field loss in bitemporal hemianopsia: peripheral vision loss affecting both eyes, resulting from a tumor-typically a pituitary adenoma- putting pressure on the optic chiasm. | |
| التخصص | Oncology, endocrinology |
أورام الغدة النخامية هي أورام تحدث في الغدة النخامية . تنقسم أورام الغدة النخامية عمومًا إلى ثلاث فئات تعتمد على عملها البيولوجي: الورم الغدي الحميد ، الورم الغدي الغازي ، والسرطانات . معظم الأورام الغدية حميدة ، وحوالي 35٪ منها غزوية وفقط 0.1٪ إلى 0.2٪ سرطانية.[1] تمثل أورام الغدة النخامية من 10٪ إلى 25٪ من جميع الأورام داخل الجمجمة ويبلغ معدل الانتشار التقديري في عموم السكان حوالي 17٪..[1][2]
تعتبر أورام الغدة النخامية غير الغازية وغير المفرزة حميدة بالمعنى الحرفي والسريري ؛ ومع ذلك ، أظهر التحليل التلوي الأخير (Fernández-Balsells، et al. 2011) للبحوث المتاحة أن هناك دراسات قليلة حتى الآن - ذات جودة رديئة - إما لدعم أو دحض هذا الافتراض.
الأورام الغدية تتجاوز 10 mm (0.39 in) في الحجم على أنه أورام غدية كبيرة ، مع تلك الأصغر من 10 mm (0.39 in) يشار إليها باسم الأورام الغدية الدقيقة . معظم أورام الغدة النخامية هي أورام غدية دقيقة ويقدر انتشارها بـ 16.7٪ (14.4٪ في دراسات التشريح و 22.5٪ في الدراسات الإشعاعية ).).[2][3] غالبًا ما تظل غالبية الأورام الغدية الدقيقة في الغدة النخامية غير مشخصة ، وغالبًا ما يتم العثور على تلك التي يتم تشخيصها على أنها اكتشاف عرضي ويشار إليها على أنها أورام عرضية.
أورام الغدة النخامية الكبيرة هي السبب الأكثر شيوعًا لقصور الغدة النخامية.[4][5]
في حين أن أورام الغدة النخامية شائعة ، وتؤثر على واحد من كل 6 من عامة السكان ، إلا أن أورام الغدة النخامية النشطة سريريًا التي تتطلب علاجًا جراحيًا نادرة ، حيث تؤثر على واحد من كل 1000 من عامة السكان..[6]
العلامات والاعراض
بدني
تسبب أورام الغدة النخامية التي تفرز الهرمونات أحد أشكال فرط الغدة النخامية. تعتمد المحددات على نوع الهرمون. تفرز بعض الأورام أكثر من هرمون واحد ، والتوليفة الأكثر شيوعًا [7] هي هرمون النمو والبرولاكتين ، والتي تظهر على شكل نمو غير متوقع للعظام وإدرار اللبن الغير متوقع (في كل من الرجال والنساء).
قد يعاني المريض المصاب بالورم النخامي من عيوب في المجال البصري ، عمى نصفي صدغي مزدوج كلاسيكي. ينشأ من ضغط الورم على العصب البصري. المنطقة المحددة من المسار البصري التي يحدث فيها انضغاط هذه الأورام هي منطقة التصالبة البصرية . يتسبب تشريح هذا الهيكل في الضغط عليه لإحداث خلل في المجال البصري الصدغي على كلا الجانبين ، وهي حالة تسمى عمى نصفي صدغي مزدوج . إذا نشأ علوي على التصالب البصري ، وهو الأكثر شيوعًا في ورم قحفي بلعومي في سويقة الغدة النخامية ، سيظهر عيب المجال البصري أولاً على شكل رباعي صدغي سفلي ، إذا كان نشأ أسفل من التصالب البصري ، سيظهر عيب المجال البصري أولاً على شكل رباعي صدغي علوي . يمكن أن يؤدي التمدد الجانبي للورم الغدي في الغدة النخامية أيضًا إلى ضغط العصب المُبَعِّد ، مما يتسبب في حدوث شلل للعضلة المستقيمة الوحشية.[8]
أيضا ، يمكن أن يسبب الورم الغدي في الغدة النخامية أعراض زيادة الضغط داخل الجمجمة . غالبًا ما تبدأ الأورام البرولاكتينية في إظهار الأعراض خاصة أثناء الحمل ، عندما يزيد هرمون البروجسترون من معدل نمو الورم.
أنواع مختلفة من الصداع شائعة في المرضى الذين يعانون من أورام الغدة النخامية. قد يكون الورم الغدي هو العامل المسبب الرئيسي وراء الصداع أو قد يؤدي إلى تفاقم الصداع الناجم عن عوامل أخرى. من بين أنواع الصداع التي يتم التعرض لها كل من الصداع النصفي المزمن والانتيابي ، والصداع أحادي الجانب المتنوع بشكل غير مألوف. الصداع الواخز الأولي,[9] نوبات الصداع العصبي أحادية الجانب قصيرة الأمد مع حقن الملتحمة ونزول الدموع (SUNCT))[10] -نوع آخر من صداع الوخز يتميز بوخزات قصيرة من الألم - ، صداع عنقودي,[11] وصداع نصفي مستمر (HS).[12]
تظهر الأعراض الانضغاطية لأورام الغدة النخامية (ضعف المجال البصري ، وانخفاض حدة البصر ، والصداع) بشكل أكثر شيوعًا مع الأورام الغدية الكبيرة (التي تزيد عن 10 مم) من الأورام الغدية الدقيقة (التي يقل قطرها عن 10 مم في القطر)..[13]
يمكن أن تستمر الأورام الغدية غير المفرزة دون أن يتم اكتشافها لفترة طويلة لأنه لا توجد تغيرات واضحة ؛ الانخفاض التدريجي في الأنشطة العادية بسبب انخفاض إنتاج الهرمونات أقل وضوحًا إلى حد ما. على سبيل المثال ، يعني عدم كفاية الهرمون الموجه لقشر الكظر أن الغدد الكظرية لن تنتج ما يكفي من الكورتيزول ، مما يؤدي إلى بطء التعافي من المرض والالتهاب والتعب المزمن ؛ يؤدي نقص هرمون النمو لدى الأطفال والمراهقين إلى تضاؤل القامة ولكن يمكن أن يكون له تفسيرات أخرى كثيرة..[citation needed]
نفسي
ارتبطت المظاهر النفسية المختلفة باضطرابات الغدة النخامية بما في ذلك أورام الغدة النخامية. وقد لوحظت أعراض نفسية مثل الاكتئاب والقلق[14] واللامبالاة وعدم الاستقرار العاطفي وسهولة الانفعال والعداء.[15]
مضاعفات

- تضخم الاطراف هي متلازمة تحدث عندما تفرز الغدة النخامية الأمامية هرمون النمو الزائد (GH). ما يقرب من 90-95٪ من حالات ضخامة الاطراف ناتجة عن ورم غدي في الغدة النخامية ، ويصيب بشكل شائع البالغين في منتصف العمر,[16] يمكن أن يؤدي تضخم الاطراف إلى تشوه شديد ، وحالات معقدة خطيرة ، وموت مبكر إذا لم يتم فحصه. يصعب تشخيص المرض الذي غالبًا ما يرتبط أيضًا بالعملقة في المراحل المبكرة ، وغالبًا ما يتم تفويته لسنوات عديدة ، حتى تصبح التغييرات في السمات الخارجية ، وخاصة في الوجه ، ملحوظة مع متوسط الوقت من ظهور الأعراض الأولية إلى أن يكون التشخيص اثني عشر عاما.[17]
- متلازمة كوشينغ هي اضطراب هرموني يسبب فرط الكورتيزول ، وهو ارتفاع مستويات الكورتيزول في الدم. مرض كوشينغ (CD) هو السبب الأكثر شيوعًا لمتلازمة كوشينغ ، وهو مسؤول عن حوالي 70٪ من الحالات.[18] ينتج القرص المضغوط عندما يتسبب الورم الغدي في الغدة النخامية في إفراز مفرط للهرمون الموجه لقشر الكظرية (ACTH) الذي يحفز الغدد الكظرية على إنتاج كميات زائدة من الكورتيزول.[19]
- قد يسبب داء كوشينغ التعب وزيادة الوزن والرواسب الدهنية حول البطن وأسفل الظهر (السمنة الجذعية) والوجه ("وجه القمر") وعلامات التمدد ( السطور ) على جلد البطن والفخذين والثديين والذراعين وفرط ضغط الدم ، عدم تحمل الجلوكوز ، وعدوي مختلفة. في النساء ، قد يسبب نموًا مفرطًا لشعر الوجه ( الشعرانية ) وعند الرجال ضعف الانتصاب . قد تشمل المظاهر النفسية الاكتئاب والقلق وسرعة الانفعال وعدم الاستقرار العاطفي. قد يؤدي أيضًا إلى صعوبات إدراكية مختلفة.
- فرط الغدة النخامية هو مرض يصيب الفص الأمامي من الغدة النخامية والذي ينتج عادة عن ورم غدي وظيفي في الغدة النخامية وينتج عنه فرط إفراز هرمونات الغدة النخامية مثل هرمون النمو ؛ البرولاكتين. ثيروتروبين. هرمون ملوتن هرمون التحوصل؛ وهرمون الموجه لقشر الكظر.
- سكتة الغدة النخامية هي حالة تحدث عندما تنزف أورام الغدة النخامية فجأة داخليًا ، مما يؤدي إلى زيادة سريعة في الحجم أو عندما يتفوق الورم على إمدادات الدم مما يؤدي إلى نخر الأنسجة وتورم الأنسجة الميتة. غالبًا ما تظهر السكتة النخامية بفقدان بصري وصداع مفاجئ وتتطلب علاجًا في الوقت المناسب غالبًا بالكورتيكوستيرويدات والتدخل الجراحي إذا لزم الأمر.[20]
- يحدث داء السكري الكاذب المركزي بسبب انخفاض إنتاج هرمون فاسوبريسين المضاد لإدرار البول الذي يسبب العطش الشديد والإفراط في إنتاج البول المخفف للغاية ( البوال) الذي يمكن أن يؤدي إلى الجفاف . يتم إنتاج الفازوبريسين في منطقة ما تحت المهاد ثم يتم نقله إلى أسفل سويقة الغدة النخامية ويتم تخزينه في الفص الخلفي للغدة النخامية التي تفرزه بعد ذلك في مجرى الدم.[21]
نظرًا لأن الغدة النخامية قريبة جدًا من الدماغ ، فقد تغزو الأورام الغدية الغازية الأم الجافية أو عظم الجمجمة أو العظم الوتدي.[22]
عوامل الخطر
تكون الورم الصماوي المتعدد
الأورام الغدية في الغدة النخامية الأمامية هي سمة سريرية رئيسيةمن تكون الورم الصماوي المتعدد من النوع 1 (MEN1) ، وهي متلازمة غدد صماء وراثية نادرة تصيب شخصًا واحدًا من كل 30000. يتسبب الورم الصماوي المتعدد في توليفات مختلفة من الأورام الحميدة أو الخبيثة في الغدد المختلفة في جهاز الغدد الصماء أو قد يتسبب في تضخم الغدد دون تكوين أورام. غالبًا ما يصيب الغدد الجار درقية وخلايا جزيرة البنكرياس والفص الأمامي من الغدة النخامية. قد يسبب الورم الصماوي المتعدد من النوع 1 أيضًا أورامًا غير صماء مثل الأورام الوعائية الليفية للوجه ، والأورام الكولاجينية ، والأورام الشحمية ، والأورام السحائية ، والأورام البطانية العصبية ، والأورام العضلية الملساء . ما يقرب من 25 في المئة من المرضى الذين يعانون من الورم الصماوي المتعدد من النوع 1 يصابون بأورام الغدة النخامية.s.[23][24]
معقد كارني
مركب كارني (معقد كارني) (CNC) ، المعروف أيضًا باسم متلازمة LAMB[25] ومتلازمة NAME[25] هو حالة جسميةصبغية سائدة تشمل الورم المخاطي للقلب والجلد ، وفرط تصبغ الجلد ( نماش ) ، وفرط نشاط الغدد الصماء، وهي تختلف عن ثالوث كارني.[26][27] ما يقرب من 7 ٪ من جميع الأورام المخاطية القلبية مرتبطة بمركب كارني.[28] المرضى الذين يعانون من CNC يطورون أورام الغدة النخامية التي تنتج هرمون النمو (GH) وفي بعض الحالات تفرز هذه الأورام نفسها أيضًا البرولاكتين . ومع ذلك ، لا توجد أورام برولاكتينية معزولة أو أي نوع آخر من أورام الغدة النخامية. في بعض المرضى الذين يعانون من CNC ، تتميز الغدة النخامية بمناطق مفرطة التنسج مع فرط تنسج يسبق على الأرجح تكوين الأورام الغدية المنتجة لـهرمون النمو.[29]
ورم الغدة النخامية المعزول العائلي
الورم الغدي النخامي المعزول العائلي (FIPA) هو مصطلح يستخدم لتحديد حالة تظهر وراثة جسمية صبغية سائدة وتتميز بوجود اثنين أو أكثر من المرضى ذوي الصلة المتأثرين بأورام الغدة النخامية فقط ، مع عدم وجود أعراض أخرى مرتبطة تحدث في أورام الغدد الصماء المتعددة من النوع 1 (MEN-1) أو مجمع كارني[30][31] تم وصف الورم الغدي النخامي المعزول العائلي لأول مرة في مجموعة محدودة من العائلات من قبل مجموعة Albert Beckers في لييج ، بلجيكا;[32] فيما بعد تميز الورم الغدي النخامي المعزول العائلي بشكل كامل في دراسة دولية متعددة المراكز شملت 64 عائلة..[31] تنقسم عائلات الورم الغدي النخامي المعزول العائلي إلى عائلات متجانسة ولديها نفس النوع من الورم الغدي في الغدة النخامية في جميع أفراد الأسرة المصابين (على سبيل المثال فقط ضخامة الأطراف ، ورم البرولاكتين فقط ، وما إلى ذلك) ، في حين أن عائلات الورم الغدي النخامي المعزول العائلي غير المتجانسة يمكن أن يكون لها أورام غدية نخامية مختلفة في أفراد الأسرة المتضررين..[33]
جينات الورم الغدي النخامي المعزول العائلي
لدى الورم الغدي النخامي المعزول العائلي سببان وراثيان معروفان ، طفرات في جين البروتين المتفاعلAIP مع مستقبلات AH [34] والازدواجية في الكروموسوم Xq26.3 التي تتضمن جين GPR101 الذي يسبب أيضًا متلازمة تضخم الاطراف (X-LAG) المرتبطة بـالكروسوم- X ..[35] حوالي 15-20 ٪ من عائلات الورم الغدي النخامي المعزول العائلي تحمل طفرة أو حذف جيني AIP في الخط الإنتاشي ، ويحدث المرض باعتباره جسميًا صبغياً سائدًا مع اختراق غير كامل ، مما يعني أن حوالي 20 ٪ من حاملي طفرة AIP سيطورون ورمًا غديًا في الغدة النخامية.[33] عادةً ما تكون أورام الغدة النخامية المرتبطة بطفرة AIP (إما تظهر على شكل ورم الغدي النخامي المعزول العائلي أو كحالات فردية وغير عائلية) عبارة عن إفراز هرمون النمو ( ضخامة الأطراف ) أو أورام البرولاكتين الغدية الكبيرة (ورم غدي كبير) وغالبًا ما تحدث عند الأطفال والمراهقين والشباب الكبار. أظهر دالي وزملاؤه أن حالات ضخامة الأطراف مع طفرات AIP حدثت قبل حوالي 20 عامًا من حالات ضخامة الأطراف بدون طفرات AIP وأن هذه الأورام كبيرة ومقاومة نسبيًا للعلاج.[36] نظرًا لصغر سنهم في البداية ، فإن طفرات AIP هي السبب الجيني الأكثر شيوعًا لعملقة الغدة النخامية (29 ٪ من الحالات).).[37]
X-LAG هي متلازمة نادرة تظهر في مرحلة الطفولة المبكرة جدًا لأورام الغدة النخامية / فرط التنسج الذي يؤدي إلى زيادة هرمون النمو وزيادة النمو الشديد والعملقة النخامية.[35][38] تم الإبلاغ عن ثلاث عائلات من الورم الغدي النخامي المعزول العائلي مصابة بـ X-LAG حتى الآن وكلها لديها انتقال لكروموسوم Xq26.3 من الأم المصابة إلى الابن المصاب.[38][35] تؤدي خصائص مرض العملقة النخامية في سن مبكرة جدًا إلى فرط النمو الشديد إذا لم يتم علاجها بشكل كافٍ ؛ العديد من أطول البشر في التاريخ (على سبيل المثال روبرت بيرشينج وادلو ساندي ألين ، أندريه روسيموف (أندريه العملاق) ، تسنغ جينليان ) لديهم تاريخ سريري مشابه لمرضى متلازمة X-LAG..[39] كان يوليوس كوخ (جيان كونستانتين) أطول شخص تاريخي له سبب وراثي معروف ، حيث وجد أنه مصاب بـ X-LAG في الدراسة الجينية لهيكله العظمي.[40] تمتلك X-LAG نسبة انتفاذ بنسبة 100٪ حتى الآن (جميع المصابين بتكرار Xq26.3 يعانون من المرض ويصيب في الغالب الإناث.[35] تمتلك X-LAG نسبة انتفاذ بنسبة 100٪ حتى الآن (جميع المصابين بتكرار Xq26.3 يعانون من المرض ويصيب في الغالب الإناث. [41] يمكن أن يكون للحالات غير العائلية المعزولة من X-LAG إما تكرار بنيوي للكروموسوم Xq26.3 بما في ذلك GPR101 ، أو الفسيفساء من أجل الازدواج (الموجود في أقلية من الخلايا) في حالة المرضى الذكور المعزولين..[42] تسبب X-LAG حوالي 10٪ من حالات العملقة النخامية ..[37]
الآلية
غالبًا ما يُشار إلى الغدة النخامية أو الغدة النخامية باسم "الغدة الرئيسية" في جسم الإنسان. جزء من محور الغدة النخامية -الوطائي ، يتحكم في معظم وظائف الغدد الصماء في الجسم عن طريق إفراز هرمونات مختلفة في الدورة الدموية . تقع الغدة النخامية أسفل الدماغ في منخفض (حفرة) من العظم الوتدي المعروف باسم السرج التركي . على الرغم من ارتباطها تشريحيًا ووظيفيًا بالدماغ ، إلا أن الغدة النخامية.تقع خارج الحاجز الدموي الدماغي . يتم فصله عن الفراغ تحت العنكبوتية بواسطة الحجاب السرجي، وبالتالي فإن الأم العنكبوتية وبالتالي السائل الدماغي الشوكي لا يمكن أن يدخل السرج التركي.
تنقسم الغدة النخامية إلى فصين ، الفص الأمامي (الذي يمثل ثلثي حجم الغدة) ، والفص الخلفي (ثلث الحجم) مفصولة بالجزء الوسط.[7]
لا يعتبر الفص الخلفي (الفص العصبي أو النخامية العصبية) للغدة النخامية ، على الرغم من اسمه ، غدة حقيقية. يحتوي الفص الخلفي على محاور عصبية تمتد من منطقة ما تحت المهاد التي يتصل بها عبر سويقة الغدة النخامية. يتم تخزين هرمونات الفازوبريسين والأوكسيتوسين ، التي تنتجها الخلايا العصبية للنواة فوق البصرية والمجاورة للبطين في منطقة ما تحت المهاد ، في الفص الخلفي ويتم إطلاقها من نهايات محور عصبي ( التغصنات ) داخل الفص.[43]
الفص الأمامي للغدة النخامية (adenohypophysis) هو غدة حقيقية تنتج وتفرز ستة هرمونات مختلفة: الهرمون المنبه للغدة الدرقية (TSH) ، الهرمون الموجه لقشر الكظر (ACTH) ، الهرمون المنبه للجريب (FSH) ، الهرمون المنشط للجسم الاصفر (LH) ، هرمون النمو (GH) ، والبرولاكتين (PRL)..[44]
التشخيص
يمكن إجراء تشخيص الورم الغدي في الغدة النخامية ، أو على الأقل الاشتباه به ، من خلال مجموعة من الأعراض ذات الصلة المعروضة أعلاه.[8]
يشمل التشخيص التفريقي التورم السلي في الغدة النخامية ، وخاصة في البلدان النامية وفي المرضى الذين يعانون من نقص المناعة..[45] يتم تأكيد التشخيص عن طريق اختبار مستويات الهرمون والتصوير الشعاعي للغدة النخامية (على سبيل المثال ، عن طريق التصوير المقطعي المحوسب أو التصوير بالرنين المغناطيسي).
التصنيف
على عكس أورام الغدة النخامية الخلفية ، تصنف الأورام الغدية في الغدة النخامية على أنها أورام الغدد الصماء (وليس أورام المخ). تصنف الأورام الغدية في الغدة النخامية على أساس المعايير التشريحية والنسيجية والوظيفية.[46]
- تصنف أورام الغدة النخامية تشريحيًا حسب حجمها بناءً على النتائج الإشعاعية ؛ إما ورم غدي صغير (أقل من 10 مم) أو ورم غدي كبير (يساوي أو أكبر من 10 مم).
- التصنيف المعتمد على النتائج التشريحية الإشعاعية يضع الأورام الغدية في 1 من 4 درجات (من الأول إلى الرابع):[47]
- المرحلة الأولى: الأورام الغدية الصغيرة (أقل من 1 سم) بدون توسع السرج.
- المرحلة الثانية: ورم غدي كبير (≥1 سم) وقد يمتد فوق السرج.
- المرحلة الثالثة: ورم غدي كبير مع تضخم وغزو القاع أو التمدد فوق السرج.
- المرحلة الرابعة هي تدمير السرج
- يستخدم التصنيف النسيجي توصيفًا مناعيًا للأورام من حيث إنتاج الهرمونات.[46] تاريخيا كانت تصنف على أنها إما أليفف للقواعد ،أليفة للحمض ، أو كاره للون على أساس ما إذا كانت أو لم تكن تناولت صبغة البقع الهيماتوكسيلين و يوزين . لقد أصبح هذا التصنيف غير مستخدم ، لصالح تصنيف يعتمد على نوع الهرمون الذي يفرزه الورم. ما يقرب من 20-25 ٪ من الأورام الغدية لا تفرز أي هرمونات نشطة يمكن التعرف عليها بسهولة ("أورام غير عاملة") ومع ذلك لا يزال يشار إليها أحيانًا باسم "كارهة اللون"..
- يعتمد التصنيف الوظيفي على نشاط الغدد الصماء للأورام على النحو الذي تحدده مستويات الهرمون في المصل وإفراز الهرمون الخلوي لأنسجة الغدة النخامية المكتشفة عن طريق التصبيغ المناعي الكيميائي.[48] قيم "النسبة المئوية لحالات إنتاج الهرمون" هي كسور الأورام الغدية التي تنتج كل هرمون مرتبط من كل نوع ورم مقارنة بجميع حالات أورام الغدة النخامية ، ولا ترتبط بشكل مباشر بالنسب المئوية لكل نوع من أنواع الورم بسبب حالات أصغر أو أكبر من عدم وجود إفراز للهرمون المتوقع. وبالتالي ، قد تكون الأورام الغدية غير المفرزة إما أورامًا غدية خالية من الخلايا أو ورمًا غديًا أكثر تحديدًا والذي ، مع ذلك ، يظل غير مفرز..
- قد يسبب أي نوع من سرطان الغدة النخامية المدرجة في الجدول أدناه أعراضًا ضاغطة بسبب التوسع الموضعي بالإضافة إلى التأثيرات الجهازية للهرمونات المفرزة المدرجة في عمود علم الأمراض.
- تأثيرات ضاغطة على سويقة الغدة النخامية (تأثير السويقة). هذا يؤدي إلى انخفاض مستويات الدوبامين من منطقة ما تحت المهاد إلى الغدة النخامية الأمامية. يمارس الدوبامين تأثيرًا مثبطًا على إفراز البرولاكتين. مع عدم وجود هذا التأثير المثبط ، تزداد مستويات البرولاكتين وغالبًا ما تزداد في أورام الخلايا الخالية من الخلايا. هذا يؤدي إلى أعراض قصور الغدد التناسلية..[13]
| نوع الورم الغدي | الافراز | الصبغة | الباثولوجي | نسبة حالات إنتاج الهرمونات | نسبة الحالات الخفية |
|---|---|---|---|---|---|
| الاورام الغدية اللبنية (ورم پرولاكتيني) | تفرز البرولاكتين | حمض | ثر اللبن, قصور الغدد التناسلية, انقطاع الطمث, العقم, و العجز الجنسي | 30%[50] | <9%[49] |
| الورم الغدي المنمي للجسم | تفرز هرمون النمو (GH) | حمض | تضخم الأطراف في البالغين; العملقة في الاطفال | 15%[50] | <9%[49] |
| منمي للقشرة
اورام غدية |
تفرز الهرمون الموجه لقشرة الغدة الكظرية (ACTH) | قعد | متلازمة كوشينگ | 2-6%[13] | 10% |
| موجه للغدد التناسلية اورام غدية | تفرز الهرمون المنشط للجسم الأصفر (LH), هرمون منبه للجريب (FSH) ومكوناتهم | قعد | عادة لا تسبب أعراض ، في بعض الأحيان فرط الغدد التناسلية[13] | 10%[50] | 73%[49] |
| موجه للدرقية
اورام غدية (نادر) |
تفرز الهرمون المحفز للدرقية (TSH) | قعد إلي كاره للون | احيانا فرط الدرقية,[51] عادة لا تسبب اعراض | أقل من 1%[50] | <9% |
| خالية من الخلايا اورام غدية | لا يفرز هرمونات | قد يكون ايجابي الصبغة لسينابتوفيسين | بدون اعراض أو قصور الغدد التناسلية[13] | o25 من أورام الغدة النخامية غير مفرزة | 1%[49] |
تتكون الأورام الغدية من الخلايا الخالية من الواسمات الحقيقية عادةً من خلايا غير نمطية موحدة بشكل معتدل مع السيتوبلازم الكاره للون. تحتوي هذه الحالة على بنية حليمية مشابهة لأورام الغدد التناسلية.[52]
أورام الغدة النخامية العرضية
أورام الغدة النخامية العرضية هي أورام الغدة النخامية التي تتميز بأنها اكتشاف عرضي. وغالبا ما يتم اكتشافها من قبل التصوير المقطعي المحوسب (CT) أو التصوير بالرنين المغناطيسي (MRI) ، أجريت في تقييم الحالات الطبية غير ذات الصلة مثل المشتبه به في اصابة الرأس ,في مراحل تطور مرض السرطان أو في تقييم أعراض غير محددة مثل الدوخة و الصداع. فإنه ليس من غير المألوف بالنسبة لهم أن يكون اكتشفت في تشريح الجثة. في التحليل التلوي، تم العثور على الأورام الغدية في المتوسط 16.7 ٪ في دراسات ما بعد الوفاة ، مع معظمها اورام غدية صغيرة (<10mm) ؛ شكلت الأورام الكبيرة 0.16٪ إلى 0.2٪ فقط من المتوفين.[2] على الرغم من عدم إفرازها ، إلا أن أورام الغدة النخامية الدقيقة غير الباضعة تعتبر بشكل عام حرفيا وكذلك سريريا حميدة، هناك حتى الآن دراسات ضئيلة ذات جودة منخفضة لدعم هذا التأكيد..[53]
أوصت جمعية الغدد الصماء - وهي منظمة طبية دولية مهنية في مجال طب الغدد الصماء والاستقلاب - في إرشادات الممارسة السريرية الحالية (2011) بأن يخضع جميع المرضى الذين يعانون من أورام الغدة النخامية لتاريخ طبي كامل وفحص جسدي وتقييمات معملية من أجل فحص لفرط إفراز الهرمونات وقصور الغدة النخامية . إذا كانت الآفة على مقربة من العصب البصري أو التصالب البصري ، فيجب إجراء فحص المجال البصري. بالنسبة لأولئك الذين يعانون من الأورام العرضية التي لا تتطلب إزالة جراحية ، يجب إجراء التقييمات السريرية والتصوير العصبي وكذلك متابعة فحوصات المجال البصري للأورام العرضية التي تتاخم أو تضغط على العصب البصري والتصالب ومتابعة اختبار الغدد الصماء لأورام العرضية الكبيرة..[54]
ورم الغدة النخامية الخارجي
الورم الغدي الخارجي (يحدث في مكان غير طبيعي) هو نوع نادر من الورم يحدث خارج السرج التركي ، غالبًا في الجيوب الوتدية,[55] المنطقة فوق السرج ، والبلعوم الأنفي ، والجيوب الكهفية.[56]
النقائل في الغدة النخامية
الأورام السرطانية التي تنتقل إلى الغدة النخامية غير شائعة وعادة ما تظهر عند كبار السن,[57][58]مع سرطان الرئة والثدي تكون أكثر انتشارًا,[59] في مرضى سرطان الثدي ، تحدث النقائل إلى الغدة النخامية في حوالي 6 - 8٪ من الحالات.[60]
تمثل نقائل الغدة النخامية المصحوبة بأعراض 7٪ فقط من الحالات المبلغ عنها. غالبًا ما يحدث مرض السكري الكاذب عند المصابين بأعراض بمعدلات تقارب 29-71٪. تشمل الأعراض الأخرى التي يتم الإبلاغ عنها بشكل شائع ضعف الغدة النخامية الأمامية وعيوب المجال البصري والصداع / الألم وشلل العين.[61]
العلاج
تعتمد خيارات العلاج على نوع الورم وحجمه:
- غالبًا ما يتم علاج أورام البرولاكتين باستخدام كابيرجولين أو كيناجوليد (كلاهما مناهضات الدوبامين) ، مما يقلل من حجم الورم ويخفف الأعراض ، ويتبع ذلك التصوير المتسلسل للكشف عن أي زيادة في الحجم. يمكن أن يكون العلاج ، حيث يكون الورم كبيرًا ، عن طريق العلاج الإشعاعي أو العلاج بالبروتونات أو الجراحة ، ويستجيب المرضى بشكل جيد بشكل عام. على عكس الأورام البرولاكتينية ، تستجيب الأورام الغدية الدرقيّة بشكل ضعيف للعلاج بمناهضات الدوبامين[51]
- تستجيب الأورام الغدية المنم للجسدية للأوكتريوتيد أو اللانريوتيد ، وهما نظائر السوماتوستاتين طويلة المفعول. تمنع نظائر مستقبلات السوماتوستاتين إفراز هرمون النمو. تم العثور على أنها فعالة بنسبة 50-55 ٪ في تقليل كتلة الورم وتقليل هرمون النمو ومستويات الأنسولين مثل عامل النمو المشابه للانسولين 1 (IGF-1) في الدراسات.[13] كما يستخدم مضاد مستقبلات هرمون النمو بيجفيسومانت في علاج الأورام الغدية المنم للجسدية. يمنع بيجفيسومانت عمل هرمون النمو. يمكن استخدامه إما كعلاج وحيد أو مع نظير السوماتوستاتين.[62]
- الجراحة هي علاج شائع لأورام الغدة النخامية. النهج الطبيعي هو استئصال الاورام الغدية عبر الوتد ، والذي عادة ما يمكن إزالة الورم دون التأثير على الدماغ أو الأعصاب البصرية.[63]
- يستخدم الإشعاع أيضًا في علاج أورام الغدية في الغدة النخامية. تشمل الأمثلة العلاج الإشعاعي بحزمة خارجية أو شعاع البروتون أو الجراحة الإشعاعية التجسيمية. يمكن للإشعاع الخارجي لأورام الغدة النخامية أن يوقف نمو الورم لعدة سنوات ، لكن فشل الغدة النخامية يتطور في غضون 10 سنوات في معظم المرضى مما يستلزم استبدال الهرمون مدى الحياة.[13] يرتبط العلاج الإشعاعي لأورام الغدة النخامية بزيادة قدرها 4 أضعاف في معدل الوفيات بسبب أمراض الأوعية الدموية الدماغية.[13]
انظر ايضا
مراجع
- ^ أ ب Pituitary Tumors Treatment (PDQ®)–Health Professional Version NIH National Cancer Institute
- ^ أ ب ت Ezzat S, Asa SL, Couldwell WT, Barr CE, Dodge WE, Vance ML, McCutcheon IE (August 2004). "The prevalence of pituitary adenomas: a systematic review". Cancer. 101 (3): 613–9. doi:10.1002/cncr.20412. PMID 15274075. S2CID 16595581.
- ^ Asa SL (August 2008). "Practical pituitary pathology: what does the pathologist need to know?". Archives of Pathology & Laboratory Medicine. 132 (8): 1231–40. doi:10.5858/2008-132-1231-PPPWDT. PMID 18684022.
- ^ Higham, Claire E; Johannsson, Gudmundur; Shalet, Stephen M (November 2016). "Hypopituitarism". The Lancet. 388 (10058): 2403–2415. doi:10.1016/S0140-6736(16)30053-8. PMID 27041067. S2CID 208791062.
- ^ Hyperthyroidism unmasked several years after the medical and radiosurgical treatment of an invasive macroprolactinoma inducing hypopituitarism: a case report. L Foppiani, A Ruelle, P Cavazzani, P del Monte - Cases Journal, 2009
- ^ Daly AF, Rixhon M, Adam C, Dempegioti A, Tichomirowa MA, Beckers A (December 2006). "High prevalence of pituitary adenomas: a cross-sectional study in the province of Liege, Belgium". The Journal of Clinical Endocrinology and Metabolism. 91 (12): 4769–75. doi:10.1210/jc.2006-1668. PMID 16968795.
- ^ أ ب Serri, O; Somma, M; Rasio, E; Brazeau, P (January 1989). "Growth hormone-releasing factor increases serum prolactin concentrations in normal subjects and in patients with pituitary adenomas". The Journal of Clinical Endocrinology and Metabolism. 30 (1): 65–75. doi:10.1111/j.1365-2265.1989.tb03728.x. PMID 2505955. S2CID 27780583. Retrieved 26 June 2021.
- ^ أ ب "Acromegaly and Gigantism". The Lecturio Medical Concept Library. Retrieved 26 June 2021.
- ^ Levy MJ, Matharu MS, Meeran K, Powell M, Goadsby PJ (August 2005). "The clinical characteristics of headache in patients with pituitary tumours". Brain. 128 (Pt 8): 1921–30. doi:10.1093/brain/awh525. PMID 15888539.
- ^ Matharu MS, Levy MJ, Merry RT, Goadsby PJ (November 2003). "SUNCT syndrome secondary to prolactinoma". Journal of Neurology, Neurosurgery, and Psychiatry. 74 (11): 1590–2. doi:10.1136/jnnp.74.11.1590. PMC 1738244. PMID 14617728.
- ^ Milos P, Havelius U, Hindfelt B (March 1996). "Clusterlike headache in a patient with a pituitary adenoma. With a review of the literature". Headache. 36 (3): 184–8. doi:10.1046/j.1526-4610.1996.3603184.x. PMID 8984093. S2CID 1681207.
- ^ Levy MJ, Matharu MS, Goadsby PJ (March 2003). "Prolactinomas, dopamine agonists and headache: two case reports". European Journal of Neurology. 10 (2): 169–73. doi:10.1046/j.1468-1331.2003.00549.x. PMID 12603293. S2CID 9475046.
- ^ أ ب ت ث ج ح خ د Longo, Dan L.; Melmed, Shlomo (5 March 2020). "Pituitary-Tumor Endocrinopathies". New England Journal of Medicine. 382 (10): 937–950. doi:10.1056/NEJMra1810772. PMID 32130815.
- ^ Sievers C, Ising M, Pfister H, Dimopoulou C, Schneider HJ, Roemmler J, Schopohl J, Stalla GK (March 2009). "Personality in patients with pituitary adenomas is characterized by increased anxiety-related traits: comparison of 70 acromegalic patients with patients with non-functioning pituitary adenomas and age- and gender-matched controls". European Journal of Endocrinology. 160 (3): 367–73. doi:10.1530/EJE-08-0896. PMID 19073833.
- ^ Weitzner MA, Kanfer S, Booth-Jones M (2005). "Apathy and pituitary disease: it has nothing to do with depression". The Journal of Neuropsychiatry and Clinical Neurosciences. 17 (2): 159–66. doi:10.1176/appi.neuropsych.17.2.159. PMID 15939968.
- ^ "Acromegaly and Gigantism". Merck.com. Retrieved 2010-10-26.
- ^ Nabarro JD (April 1987). "Acromegaly". Clinical Endocrinology. 26 (4): 481–512. doi:10.1111/j.1365-2265.1987.tb00805.x. PMID 3308190. S2CID 221550204.
- ^ Cushing’s Syndrome Archived 2011-04-10 at the Wayback Machine at The National Endocrine and Metabolic Diseases Information Service. July 2008. In turn citing: Nieman LK, Ilias I (December 2005). "Evaluation and treatment of Cushing's syndrome". The American Journal of Medicine. 118 (12): 1340–6. doi:10.1016/j.amjmed.2005.01.059. PMID 16378774.
- ^ Kirk LF, Hash RB, Katner HP, Jones T (September 2000). "Cushing's disease: clinical manifestations and diagnostic evaluation". American Family Physician. 62 (5): 1119–27, 1133–4. PMID 10997535.
- ^ Biousse V, Newman NJ, Oyesiku NM (October 2001). "Precipitating factors in pituitary apoplexy". Journal of Neurology, Neurosurgery, and Psychiatry. 71 (4): 542–5. doi:10.1136/jnnp.71.4.542. PMC 1763528. PMID 11561045.
- ^ Maghnie M (2003). "Diabetes insipidus". Hormone Research. 59 Suppl 1: 42–54. doi:10.1159/000067844. PMID 12566720. S2CID 24638358.
- ^ National Center for Biotechnology Information, U.S. National Library of Medicine https://www.ncbi.nlm.nih.gov/books/NBK551529/. Retrieved 26 June 2021.
{{cite web}}: Missing or empty|title=(help) - ^ Newey PJ, Thakker RV (2011). "Role of multiple endocrine neoplasia type 1 mutational analysis in clinical practice". Endocrine Practice. 17 Suppl 3: 8–17. doi:10.4158/EP10379.RA. PMID 21454234.
- ^ Marini F, Falchetti A, Luzi E, Tonelli F, Maria Luisa B (2009). "Multiple Endocrine Neoplasia Type 1 (MEN1) Syndrome". In Riegert-Johnson DL (ed.). Cancer Syndromes. National Center for Biotechnology Information (US). PMID 21249756.
- ^ أ ب Carney Syndrome at eMedicine
- ^ Carney JA, Gordon H, Carpenter PC, Shenoy BV, Go VL (July 1985). "The complex of myxomas, spotty pigmentation, and endocrine overactivity". Medicine. 64 (4): 270–83. doi:10.1097/00005792-198507000-00007. PMID 4010501. S2CID 20522398.
- ^ McCarthy PM, Piehler JM, Schaff HV, Pluth JR, Orszulak TA, Vidaillet HJ, Carney JA (March 1986). "The significance of multiple, recurrent, and "complex" cardiac myxomas". The Journal of Thoracic and Cardiovascular Surgery. 91 (3): 389–96. doi:10.1016/S0022-5223(19)36054-4. PMID 3951243.
- ^ Reynen K (December 1995). "Cardiac myxomas". The New England Journal of Medicine. 333 (24): 1610–7. doi:10.1056/NEJM199512143332407. PMID 7477198.
- ^ Stergiopoulos SG, Abu-Asab MS, Tsokos M, Stratakis CA (2004). "Pituitary pathology in Carney complex patients". Pituitary. 7 (2): 73–82. doi:10.1007/s11102-005-5348-y. PMC 2366887. PMID 15761655.
- ^ Daly AF, Vanbellinghen J, Beckers A (2007). "Characteristics of Familial Isolated Pituitary Adenomas". Expert Review of Endocrinology & Metabolism. 2 (6): 725–33. doi:10.1586/17446651.2.6.725. PMID 30290472. S2CID 52924983.
- ^ أ ب Daly AF, Jaffrain-Rea ML, Ciccarelli A, Valdes-Socin H, Rohmer V, Tamburrano G, et al. (September 2006). "Clinical characterization of familial isolated pituitary adenomas". The Journal of Clinical Endocrinology and Metabolism. 91 (9): 3316–23. doi:10.1210/jc.2005-2671. PMID 16787992.
- ^ Valdes-Socin, Hernan & Poncin, J & Stevens, V & Stevenaert, Achille & Beckers, A. (2000). Familial isolated pituitary adenomas unrelated to MEN1 mutations: A follow-up of 27 patients. Ann Endocrinol (Paris). 61.
- ^ أ ب Beckers A, Aaltonen LA, Daly AF, Karhu A (April 2013). "Familial isolated pituitary adenomas (FIPA) and the pituitary adenoma predisposition due to mutations in the aryl hydrocarbon receptor interacting protein (AIP) gene". Endocrine Reviews. 34 (2): 239–77. doi:10.1210/er.2012-1013. PMC 3610678. PMID 23371967.
- ^ Daly AF, Vanbellinghen JF, Khoo SK, Jaffrain-Rea ML, Naves LA, Guitelman MA, et al. (May 2007). "Aryl hydrocarbon receptor-interacting protein gene mutations in familial isolated pituitary adenomas: analysis in 73 families". The Journal of Clinical Endocrinology and Metabolism. 92 (5): 1891–6. doi:10.1210/jc.2006-2513. PMID 17244780.
- ^ أ ب ت ث Trivellin G, Daly AF, Faucz FR, Yuan B, Rostomyan L, Larco DO, et al. (December 2014). "Gigantism and acromegaly due to Xq26 microduplications and GPR101 mutation". The New England Journal of Medicine. 371 (25): 2363–74. doi:10.1056/nejmoa1408028. PMC 4291174. PMID 25470569.
- ^ Daly AF, Tichomirowa MA, Petrossians P, Heliövaara E, Jaffrain-Rea ML, Barlier A, et al. (November 2010). "Clinical characteristics and therapeutic responses in patients with germ-line AIP mutations and pituitary adenomas: an international collaborative study". The Journal of Clinical Endocrinology and Metabolism. 95 (11): E373–83. doi:10.1210/jc.2009-2556. PMID 20685857.
- ^ أ ب Rostomyan L, Daly AF, Petrossians P, Nachev E, Lila AR, Lecoq AL, et al. (October 2015). "Clinical and genetic characterization of pituitary gigantism: an international collaborative study in 208 patients". Endocrine-Related Cancer. 22 (5): 745–57. doi:10.1530/ERC-15-0320. PMC 6533620. PMID 26187128.
- ^ أ ب Beckers A, Lodish MB, Trivellin G, Rostomyan L, Lee M, Faucz FR, et al. (June 2015). "X-linked acrogigantism syndrome: clinical profile and therapeutic responses". Endocrine-Related Cancer. 22 (3): 353–67. doi:10.1530/ERC-15-0038. PMC 4433400. PMID 25712922.
- ^ Beckers A, Rostomyan L, Potorac I, Beckers P, Daly AF (June 2017). "X-LAG: How did they grow so tall?". Annales d'Endocrinologie. 78 (2): 131–136. doi:10.1016/j.ando.2017.04.013. hdl:2268/210037. PMID 28457479.
- ^ Beckers A, Fernandes D, Fina F, Novak M, Abati A, Rostomyan L, Thiry A, Ouafik L, Pasture B, Pinhasi R, Daly AF (February 2017). "Paleogenetic study of ancient DNA suggestive of X-linked acrogigantism". Endocrine-Related Cancer. 24 (2): L17–L20. doi:10.1530/ERC-16-0558. PMID 28049632.
- ^ "Gigantism and acromegaly due to Xq26 microduplications and GPR101 mutation". The New England Journal of Medicine. 371 (25): 2363–74. December 2014. doi:10.1056/nejmoa1408028. PMID 25470569.
{{cite journal}}: Unknown parameter|PMCID=ignored (|pmc=suggested) (help); Unknown parameter|displayauthors=ignored (|display-authors=suggested) (help) - ^ Daly AF, Yuan B, Fina F, Caberg JH, Trivellin G, Rostomyan L, de Herder WW, Naves LA, Metzger D, Cuny T, Rabl W, Shah N, Jaffrain-Rea ML, Zatelli MC, Faucz FR, Castermans E, Nanni-Metellus I, Lodish M, Muhammad A, Palmeira L, Potorac I, Mantovani G, Neggers SJ, Klein M, Barlier A, Liu P, Ouafik L, Bours V, Lupski JR, Stratakis CA, Beckers A (April 2016). "Somatic mosaicism underlies X-linked acrogigantism syndrome in sporadic male subjects". Endocrine-Related Cancer. 23 (4): 221–33. doi:10.1530/ERC-16-0082. PMC 4877443. PMID 26935837.
- ^ Nussey, S.S; S.A. (2001). Endocrinology: An Integrated Approach. Oxford: BIOS Scientific Publishers. ISBN 978-0-203-45043-7.[صفحة مطلوبة]
- ^ Zhao Y, Mailloux CM, Hermesz E, Palkóvits M, Westphal H (January 2010). "A role of the LIM-homeobox gene Lhx2 in the regulation of pituitary development". Developmental Biology. 337 (2): 313–23. doi:10.1016/j.ydbio.2009.11.002. PMC 2832476. PMID 19900438.
- ^ Saini KS, Patel AL, Shaikh WA, Magar LN, Pungaonkar SA (August 2007). "Magnetic resonance spectroscopy in pituitary tuberculoma" (PDF). Singapore Medical Journal. 48 (8): 783–6. PMID 17657390.
- ^ أ ب Ironside JW (August 2003). "Best Practice No 172: pituitary gland pathology". Journal of Clinical Pathology. 56 (8): 561–8. doi:10.1136/jcp.56.8.561. PMC 1770019. PMID 12890801.
- ^ Asa SL, Ezzat S (December 1998). "The cytogenesis and pathogenesis of pituitary adenomas". Endocrine Reviews. 19 (6): 798–827. doi:10.1210/er.19.6.798. PMID 9861546.
- ^ Scanarini M, Mingrino S (1980). "Functional classification of pituitary adenomas". Acta Neurochirurgica. 52 (3–4): 195–202. doi:10.1007/BF01402074. PMID 7424602. S2CID 8095432.
- ^ أ ب ت ث ج Type as determined by transcription factors and cellular hormones:
Drummond, Juliana; Roncaroli, Federico; Grossman, Ashley B; Korbonits, Márta (2019). "Clinical and Pathological Aspects of Silent Pituitary Adenomas". The Journal of Clinical Endocrinology & Metabolism. 104 (7): 2473–2489. doi:10.1210/jc.2018-00688. ISSN 0021-972X. PMC 6517166. PMID 30020466. - ^ أ ب ت ث ج Reddy, S. Sethu K.; Hamrahian, Amir H. (2009). "Pituitary Disorders and Multiple Endocrine Neoplasia Syndromes". In Stoller, James K.; Michota, Franklin A.; Mandell, Brian F. (eds.). The Cleveland Clinic Foundation Intensive Review of Internal Medicine. Hagerstwon, MD: Lippincott Williams & Wilkins. pp. 525–35. ISBN 978-0-7817-9079-6.
- ^ أ ب Chanson P, Weintraub BD, Harris AG (August 1993). "Octreotide therapy for thyroid-stimulating hormone-secreting pituitary adenomas. A follow-up of 52 patients". Annals of Internal Medicine. 119 (3): 236–40. doi:10.7326/0003-4819-119-3-199308010-00010. PMID 8323093. S2CID 27660512.
- ^ Drummond, Juliana; Roncaroli, Federico; Grossman, Ashley B; Korbonits, Márta (2019). "Clinical and Pathological Aspects of Silent Pituitary Adenomas". The Journal of Clinical Endocrinology & Metabolism. 104 (7): 2473–2489. doi:10.1210/jc.2018-00688. ISSN 0021-972X. PMC 6517166. PMID 30020466.
- "This article has been published under the terms of the Creative Commons Attribution License (CC BY; https://creativecommons.org/licenses/by/4.0/)" - ^ Fernández-Balsells MM, Murad MH, Barwise A, Gallegos-Orozco JF, Paul A, Lane MA, Lampropulos JF, Natividad I, Perestelo-Pérez L, Ponce de León-Lovatón PG, Erwin PJ, Carey J, Montori VM (April 2011). "Natural history of nonfunctioning pituitary adenomas and incidentalomas: a systematic review and metaanalysis". The Journal of Clinical Endocrinology and Metabolism. 96 (4): 905–12. doi:10.1210/jc.2010-1054. PMID 21474687.
- ^ Freda PU, Beckers AM, Katznelson L, Molitch ME, Montori VM, Post KD, Vance ML (April 2011). "Pituitary incidentaloma: an endocrine society clinical practice guideline". The Journal of Clinical Endocrinology and Metabolism. 96 (4): 894–904. doi:10.1210/jc.2010-1048. PMC 5393422. PMID 21474686.
- ^ Thompson LD, Seethala RR, Müller S (March 2012). "Ectopic sphenoid sinus pituitary adenoma (ESSPA) with normal anterior pituitary gland: a clinicopathologic and immunophenotypic study of 32 cases with a comprehensive review of the English literature". Head and Neck Pathology. 6 (1): 75–100. doi:10.1007/s12105-012-0336-9. PMC 3311955. PMID 22430769.
- ^ Leon Barnes: Pathology and genetics of head and neck tumours; p.100: World Health Organization; (2005) ISBN 92-832-2417-5
- ^ Weil RJ (December 2002). "Pituitary metastasis". Archives of Neurology. 59 (12): 1962–3. doi:10.1001/archneur.59.12.1962. PMID 12470187.
- ^ Bret P, Jouvet A, Madarassy G, Guyotat J, Trouillas J (May 2001). "Visceral cancer metastasis to pituitary adenoma: report of two cases". Surgical Neurology. 55 (5): 284–90. doi:10.1016/S0090-3019(01)00447-5. PMID 11516470.
- ^ Morita A, Meyer FB, Laws ER (July 1998). "Symptomatic pituitary metastases". Journal of Neurosurgery. 89 (1): 69–73. doi:10.3171/jns.1998.89.1.0069. PMID 9647174.
- ^ Daniel R. Fassett, M.D.; William T. Couldwell, M.D., PhD;Medscape:Metastases to the Pituitary Gland [1]
- ^ Komninos J, Vlassopoulou V, Protopapa D, Korfias S, Kontogeorgos G, Sakas DE, Thalassinos NC (February 2004). "Tumors metastatic to the pituitary gland: case report and literature review". The Journal of Clinical Endocrinology and Metabolism. 89 (2): 574–80. doi:10.1210/jc.2003-030395. PMID 14764764.
- ^ Neggers, Sebastian J.C.M.M.; Muhammad, Ammar; van der Lely, Aart Jan (2016). "Pegvisomant Treatment in Acromegaly". Neuroendocrinology. 103 (1): 59–65. doi:10.1159/000381644. PMID 25792221. S2CID 19588354.
- ^ Transsphenoidal Surgery FAQ Neuroendocrine Clinical Center, Massachusetts General Hospital/Harvard Medical School. Retrieved November 25, 2016
وصلات خارجية
| Classification | |
|---|---|
| External resources |
- CS1 errors: missing title
- CS1 errors: bare URL
- CS1 errors: unsupported parameter
- مقالات بالمعرفة بحاجة لذكر رقم الصفحة بالمصدر from September 2013
- الصفحات بخصائص غير محلولة
- Short description is different from Wikidata
- Articles with unsourced statements from August 2020
- أورام الغدد الصماء
- علم الغدد الصماء العصبي

![تتكون الأورام الغدية من الخلايا الخالية من الواسمات الحقيقية عادةً من خلايا غير نمطية موحدة بشكل معتدل مع السيتوبلازم الكاره للون. تحتوي هذه الحالة على بنية حليمية مشابهة لأورام الغدد التناسلية.[52]](/w/images/thumb/4/40/Histopathology_of_a_true_null_cell_adenoma.jpg/120px-Histopathology_of_a_true_null_cell_adenoma.jpg)